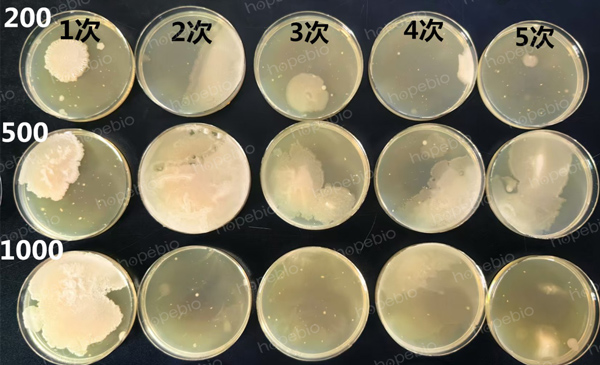

海博微信公众号
海博微信公众号
 海博天猫旗舰店
海博天猫旗舰店


 海博微信公众号
海博微信公众号
 海博天猫旗舰店
海博天猫旗舰店




一、问题
有客户反馈,购买某需煮沸灭菌的培养基,往粉末中加开水,煮沸不超过1分钟,经常出现污染。还有客户反馈,不知道怎么样算是煮沸。
本文就煮沸灭菌培养基的制备方法和操作要领再做系统试验展示,以方便广大试验操作人员能熟练掌握这一方法。
二、试验方案
1、有关培养基怎样完全溶解的试验
取两种常见的培养基,VRBA和XLD,用同样的煮沸方法,分别煮至不同的温度和次数,对倒成的平板进行强度测试,从侧面反应培养基煮沸溶解的效果。
2、有关培养基能否灭菌彻底的试验
取三种培养基,VRBA、XLD和TSA,前两种为常见的煮沸灭菌培养基,TSA为常规需要高压灭菌的培养基。用同样的煮沸方法,分别煮沸不同的次数,将倒成的平板进行空培养,观察菌落生长情况,以直观把握培养基是否灭菌彻底。
三、试验操作与结果
1、强度试验
(1)称取一定量的VRBA干粉,按比例加入纯化水(凉水),充分搅拌,无成团现象后,进行加热。分别加热至60℃、70℃、80℃、90℃、100℃煮沸1次、100℃煮沸2次、100℃煮沸3次,倾倒平板,测定其强度。结果如下(表1、图1),低于100℃的情况下,倒出的平板强度较低,甚至不能完全凝固,不能满足要求。煮至100℃,平板强度明显增大,且随着煮沸次数的增多,平板强度值也会增高。至少煮沸3次,平板强度趋于稳定。
表1 VRBA培养基煮至不同温度制成的平板的强度
|
组别 |
温度(℃) |
强度 |
分析 |
|
1 |
60 |
170 |
强度过低,部分溶解 |
|
2 |
70 |
156 |
|
|
3 |
80 |
641 |
强度尚可,未溶透 |
|
4 |
90 |
662 |
|
|
5 |
100-1 |
709 |
强度高,煮沸次数越多,溶解越充分 |
|
6 |
100-2 |
720 |
|
|
7 |
100-3 |
760 |

图1 VRBA培养基煮至不同温度制成的平板的强度
(2)分别按照比例配制200mL、500mL、1000mL的VRBA培养基和XLD培养基,每个容量级分别加热煮沸1-5次,倾倒成平板后测其强度,结果如下(表2、图2),煮沸3次,强度明显增高,且煮沸次数越多,平板强度越高。煮沸至三次,平板强度趋于稳定。不同配制量的培养基,如200mL、500mL和1000mL,煮沸相同的次数,平板强度无明显差异,所以,不管配制量多少,只要培养基煮沸次数够多,即培养基充分煮透,即可满足要求。从强度来看,至少应煮沸3次。
表2 不同量的培养基煮沸不同次数制成的平板强度
|
培养基 |
煮沸次数 |
煮沸量与强度 |
||
|
200 mL |
500 mL |
1000 mL |
||
|
VRBA |
1 |
628 |
592 |
633 |
|
2 |
617 |
579 |
622 |
|
|
3 |
664 |
669 |
648 |
|
|
4 |
663 |
666 |
716 |
|
|
5 |
674 |
751 |
673 |
|
|
XLD |
1 |
816 |
742 |
760 |
|
2 |
771 |
753 |
770 |
|
|
3 |
756 |
769 |
702 |
|
|
4 |
857 |
764 |
819 |
|
|
5 |
799 |
821 |
790 |
|

图2-1 不同量的VRBA培养基煮沸不同次数制成的平板强度

图2-2 不同量的XLD培养基煮沸不同次数制成的平板强度
图2 不同量的培养基煮沸不同次数制成的平板强度
2、灭菌试验
三种培养基,不同用量分别煮沸不同的次数制成的平板,空培养后的菌落生长情况如下(图3),VRBA和XLD煮沸1-5次,平板上均无菌落生长,常规需要高压灭菌的TSA培养基煮沸1-5次,平板上均有菌落生长。因此,一般的培养基不能用煮沸的方法进行灭菌,但VRBA、XLD之类的选择性培养基,采用煮沸灭菌的方法完全可行,可有效杀灭细菌。从灭菌彻底性来说,只要煮沸1次即可满足要求。为确保万无一失,建议尽量多煮沸几次。

图3-1 VRBA培养基平板培养结果

图3-2 XLD培养基平板培养结果
图3-3 TSA培养基平板培养结果
图3 三种培养基平板空培养的结果
四、结论和煮沸状态展示
从上面的试验可以看出,为了保证煮沸灭菌的完全溶解性和彻底灭菌性,至少应该煮沸3次。
不同煮沸次数时,培养基的状态如图4,三种培养基均表现为:煮沸1次,泡沫多而密集;煮沸3次泡沫减少,仍布满整个液面;煮沸5次,泡沫更少,中心能看到液体。所以,为减少泡沫的产生,应该尽量多煮几次,至少煮沸3次。
综合以上各方面考虑,实际操作中通常煮4-6次。
实际工作中,每次煮沸的培养基的量可能会有很大差异,煮沸的指标是以煮沸次数来定的,不是以煮沸时间来判断的,只要次数足够,一定能煮出合格好用的培养基。
有关煮沸操作的其它细节,请参考“干粉培养基煮沸灭菌的操作方法及注意事项”,相关视频可参考“培养基的加热灭菌操作”。

图4 培养基煮沸不同次数后呈现的状态
注:本文属海博生物原创,未经允许不得转载。
上一篇:BS琼脂、品红亚硫酸钠琼脂平板颜色变化的影响因素和防止颜色变化的方法
下一篇:常见问题答疑(培养结果与观察2)
| 相关文章: | ||



